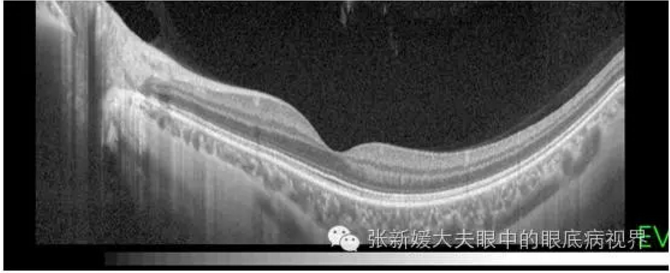
OCT究竟是什么鬼_眼部疾病_眼部疾病检查 - 好

最新OCT职位招聘信息由猎才医药网提供,为OCT人才提供便捷的医药求职服务,合作热线:025-68678201。 职位名 地点 企业规模 不限 不限 1-49人 50-99人 100-499人 500-999

oct是什么意思
780x425 - 88KB - JPEG

元投影于深圳OCT创展中心隆重发布,深圳华侨
500x335 - 31KB - JPEG

*图文* OCT 28,2006 游海上世界 - 东东的成长家
800x600 - 105KB - JPEG
OCT究竟是什么鬼_眼部疾病_眼部疾病检查 - 好
670x273 - 141KB - PNG

朱锫:深圳OCT创意展示中心即将竣工-中国设计
818x614 - 24KB - JPEG

元投影于深圳OCT创展中心隆重发布
550x366 - 23KB - JPEG

最新一代傅立叶OCT
543x543 - 16KB - JPEG

OCT.天梯。--重阳登高广州塔
525x749 - 117KB - JPEG

正常眼底高清图_正常眼底黄斑oct图_正常眼底
400x355 - 199KB - JPEG

In this Oct. 1, 2013 photo, Ashaninka Indian wo
749x421 - 44KB - JPEG

西贡,越南-Oct 12: 身份不明的年轻人享受 p - 图
449x299 - 87KB - JPEG

河南登封,CHINA-OCT 21:一位身份不明的小和
450x320 - 54KB - JPEG

看当代艺术如何解释电影 OCT艺术中心展览开
350x195 - 53KB - JPEG
流行PRA,TAK -泰国OCT24:赫蒙族身份不明的
300x470 - 76KB - JPEG
美索,达克,泰国- OCT31:身份不明的男子在街对
450x320 - 56KB - JPEG